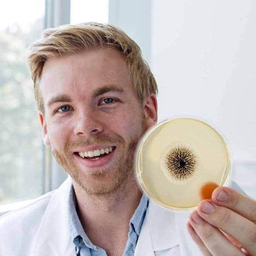

Timo Singer
Angestellt, Digitalisierungsmanager, Landratsamt Ludwigsburg
Abschluss: BSc, FH Wiener Neustadt
Ludwigsburg, Deutschland
Fähigkeiten und Kenntnisse
Werdegang
Berufserfahrung von Timo Singer
- Bis heute 3 Jahre und 10 Monate, seit März 2022
Digitalisierungsmanager
Landratsamt Ludwigsburg
- 10 Monate, Juni 2021 - März 2022
Hygienekontrolleur
Gesundheitsamt Ludwigsburg
- 2 Jahre und 1 Monat, Mai 2019 - Mai 2021
Textilprüfer
Hohenstein Textile Testing Institute GmbH & Co. KG
- 8 Monate, Juli 2017 - Feb. 2018
Laborassistent
Umweltbundesamt Wien
- 6 Monate, Okt. 2015 - März 2016
Laborant
Kwizda Pharma GmbH
- 1 Jahr und 9 Monate, Sep. 2013 - Mai 2015
CTA
Hohenstein Textile Testing Institute GmbH & Co. KG
Ausbildung von Timo Singer
- 2 Jahre und 10 Monate, Sep. 2015 - Juni 2018
Biotechnische Verfahren
FH Wiener Neustadt
- 1 Jahr und 11 Monate, Sep. 2011 - Juli 2013
Chemie
Institut Dr. Flad
Sprachen
Deutsch
Muttersprache
Englisch
Gut
Schwäbisch
Muttersprache
XING Mitglieder mit ähnlichen Profilangaben
XING – Das Jobs-Netzwerk
Über eine Million Jobs
Entdecke mit XING genau den Job, der wirklich zu Dir passt.
Persönliche Job-Angebote
Lass Dich finden von Arbeitgebern und über 20.000 Recruiter·innen.
21 Mio. Mitglieder
Knüpf neue Kontakte und erhalte Impulse für ein besseres Job-Leben.
Kostenlos profitieren
Schon als Basis-Mitglied kannst Du Deine Job-Suche deutlich optimieren.